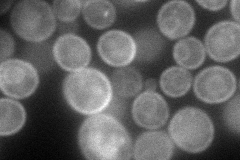
YJL219W
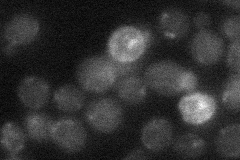
YJL219W
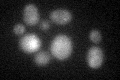
YJL219W
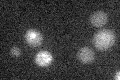
YJL219W

View description
Putative hexose transporter that is nearly identical to Hxt11p, has similarity to major facilitator superfamily (MFS) transporters, expression of HXT9 is regulated by transcription factors Pdr1p and Pdr3p
Localization:
Intensity:
Fold change:
Significance:
-
C’ GFP library in SD

below threshold14.55 -
N' NOP1pr-GFP in SD
cell periphery,ER99.2723 -
N' TEF2pr-mCherry in SD

cell periphery,vacuole158.953 -
N' NATIVEpr-GFP in SD
below threshold18.2371 -
N' TEF2pr-VC and Cyto-VN in SD

nucleus31.0446 -
C’ GFP library in SD+DTT
cytosol15.291.05No -
C’ GFP library in SD+H2O2

cytosol15.81.08No -
C’ GFP library in Starvation Media
cytosol17.421.19No -
C’ GFP library on the background of Pup2-DaMP

below threshold -
C’ GFP library on the background of CCT mutant

below threshold14.67921.00857No
